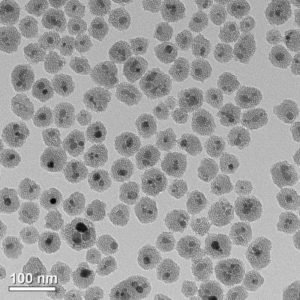
-

La criopreservación es un proceso que se encarga de congelar órganos y tejidos en una temperatura muy baja, con el fin de preservarlos lo cual es posible pero en el proceso de descongelación hay problemas, ya que se forman cristales de hielo, que dañan los tejidos.
Ahora científicos de la Universidad de Minessota liderados por John Bischof lograron grandes avances al respecto. Utilizando una nueva técnica, los científicos han podido criopreservar partes humanas y de cerdo, además de descongelarlos y preservar los tejidos intactos.
“Esta es la primera vez que alguien ha podido escalar hasta un sistema biológico más grande y demostrar un calentamiento exitoso, rápido y uniforme de cientos de grados Celsius por minuto de tejido preservado sin dañar el tejido.” comento John Bischof.
Una imagen de microscopía electrónica de transmisión muestra las nanopartículas de óxido de hierro revestidas con sílice mesoporosa que se usan en el proceso de calentamiento del tejido.
Mediante el uso de nanopartículas para calentar los tejidos a un ritmo igual, los científicos fueron capaces de prevenir la formación de cristales de hielo destructivos. Mezclaron nanopartículas de óxido de hierro revestidas con sílice en una solución y aplicaron un campo magnético externo para generar calor. El proceso se ensayó en varias muestras de tejido humano y de cerdo, y mostró que el nanocalentamiento alcanza la misma velocidad de descongelación que el uso de técnicas convencionales de convección.
Estas pruebas se realizaron en distintos tejidos humanos y de cerdos, logrando que las nano partículas fueran, hasta la fecha, la solución más efectiva al problema de descongelamiento.
Estos avances podrían ayudarnos a mejorar el sistema de transplantes de órganos, debido a que muchas personas donan sus órganos pero la logística para llevarlos al lugar necesario muchas veces no es posible por el periodo que soporta estar vivo el órgano fuera del cuerpo humano.







